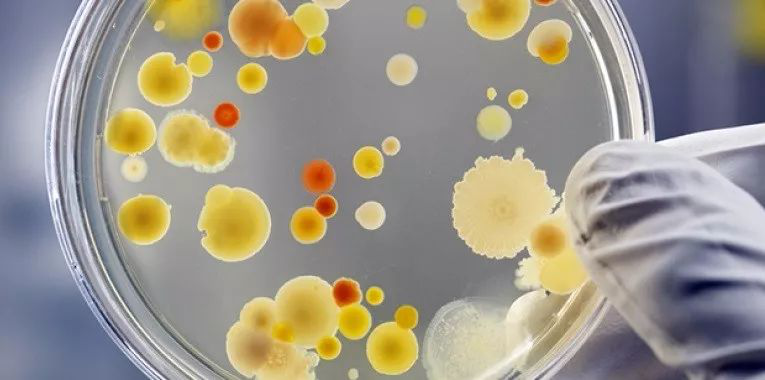
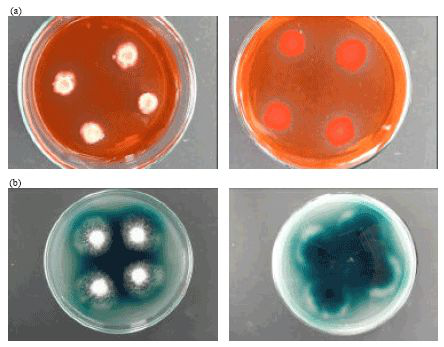

天然色素具有安全无毒性、无致癌性和可生物降解等特点,随着各国对绿色环保产品的追求,天然色素在市场上的需求逐年增加,单单依靠动植物中的提取已经不能满足人类的需求。而微生物的分布广,种类繁多,因此,微生物染色在纺织领域具有广阔的应用前景。

微生物色素
微生物色素是微生物的一种次级代谢产物,色素颜色种类较多,有红、橙、黄、绿、青、紫、黑、棕等各种颜色。微生物色素可以分为水溶性和非水溶性色素两种。与其他天然染料相比,微生物色素的生产周期短,成本低廉,更易于工业化生产。

微生物色素的产生方式主要有两种,一种是微生物生长过程中的分泌物,另一种是以培养基中的某一成分作为底物进行转化而形成的色素。对于后者,需要在培养基中加入色素产生需要的物质,促进色素生成,提高色素产量。

微生物染色方法
萃取液染色法
萃取染色法就是用液体培养基培养微生物,使之代谢出大量的色素,并经过分离、萃取和浓缩的过程,得到色素溶液。

所得色素溶液既可以直接作为染液使用,也可以被制成色素粉末使用。萃取液染色法的优点是适用范围广,易于工业化生产,缺点是提取工艺繁琐,成本较高。
菌体染色法
菌体染色法因培养基的不同而分为两种方式。一种是液体发酵培养液,当微生物代谢出大量色素时,直接将无菌织物放入培养液中培养染色;另一种是固体琼脂培养基,经过一段时间培养,微生物代谢出大量色素时,将菌体和培养基内加入水,煮沸,然后再将织物在80℃条件下染色。

菌体染色法的优点是工艺简单,省时省力,易于操作,缺点是不适用于产生非水溶性色素的微生物。
微生物天然染料由于其生态环保、发酵工艺成熟、生物相容性好等优点,越来越受到人们的喜爱。采用微生物染料对纺织品进行染色加工,染色工艺多样,色泽独特,显示出了巨大的应用前景。
(本网尊重各兄弟网站及独立撰稿人之版权,如发现本网刊登您的稿件而未署名,请联系我们.同时本网也欢迎对市场具有敏锐判断和独立见解的行业人士前来投稿,投稿邮箱info@168tex.com
电话:0512-63082910)
 苏公网安备:32050902100442号|
苏公网安备:32050902100442号|
 国家电子商务试点企业
国家电子商务试点企业 国家财政部重点扶持项目
国家财政部重点扶持项目 国家中小企业公共服务示范平台
国家中小企业公共服务示范平台 江苏省软件企业
江苏省软件企业